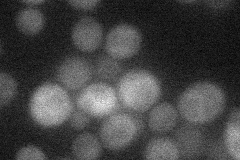
YAL061W
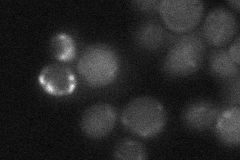
YAL061W
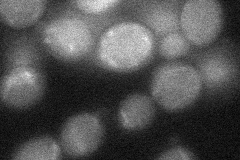
YAL061W
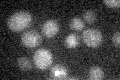
YAL061W

View description
Putative medium-chain alcohol dehydrogenase with similarity to BDH1; transcription induced by constitutively active PDR1 and PDR3
Localization:
Intensity:
Fold change:
Significance:
-
C’ GFP library in SD

cytosol20.76 -
N' NOP1pr-GFP in SD

cytosol48.9893 -
N' TEF2pr-mCherry in SD
cytosol17.0561 -
N' NATIVEpr-GFP in SD
below threshold17.9768 -
N' TEF2pr-VC and Cyto-VN in SD
below threshold26.6528 -
C’ GFP library in SD+DTT

cytosol18.510.89No -
C’ GFP library in SD+H2O2

cytosol22.371.07No -
C’ GFP library in Starvation Media
cytosol14.820.71No -
C’ GFP library on the background of Pup2-DaMP

cytosol -
C’ GFP library on the background of CCT mutant

cytosol22.13541.06587No
